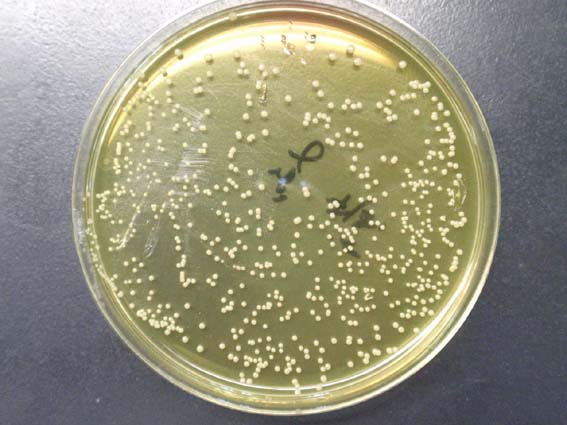

|
【質問】
マンニット食塩培地で出現したコロニーを水酸化カリウム法で試験したところ,
粘性をおびました。培地は黄色に変色しました。水酸化カリウム法より“グラム陰性菌”と思われるのですが,
マンニット食塩培地で出現するグラム陰性菌にはどのようなものがあるのでしょうか。よろしくお願いします。
【回答】
Bergey’s Manualでグラム陰性菌, 7.5%NaClでの増殖, マンニット分解を調べますと,
Vibrio属やSerratia属の菌がありました。これらの細菌は食品からしばしば分離されます。さらに,
Bacillus属も疑う必要があると思います。Bacillus属は一般的にはグラム陽性桿菌
(通常は新鮮培養菌をグラム染色します) として知られていますが, 培地上に増殖させたままにして古くなると,
グラム染色をした場合, グラム陰性に染まることがあり, このような菌集落で劉氏法
(3%KOH) を行うと, 陰性の反応が見られることがあります。劉氏法は菌形態を観察できないため,
グラム染色して顕微鏡で観察することをルーチン化することをお勧めします。
(日水製薬・小高 秀正)
【読者からのお礼】
丁寧な回答ありがとうございました。TCBS培地での培養やグラム染色を行ってみます。
|戻る|
|